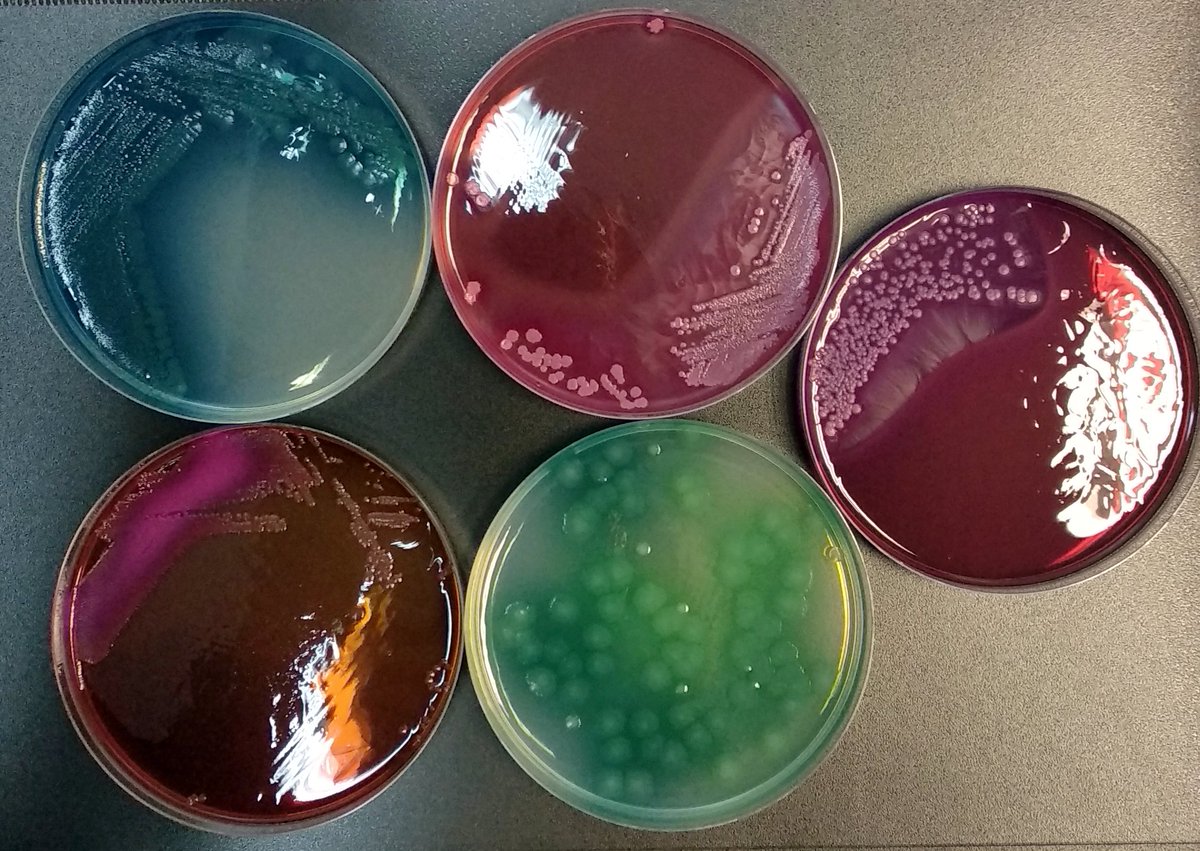
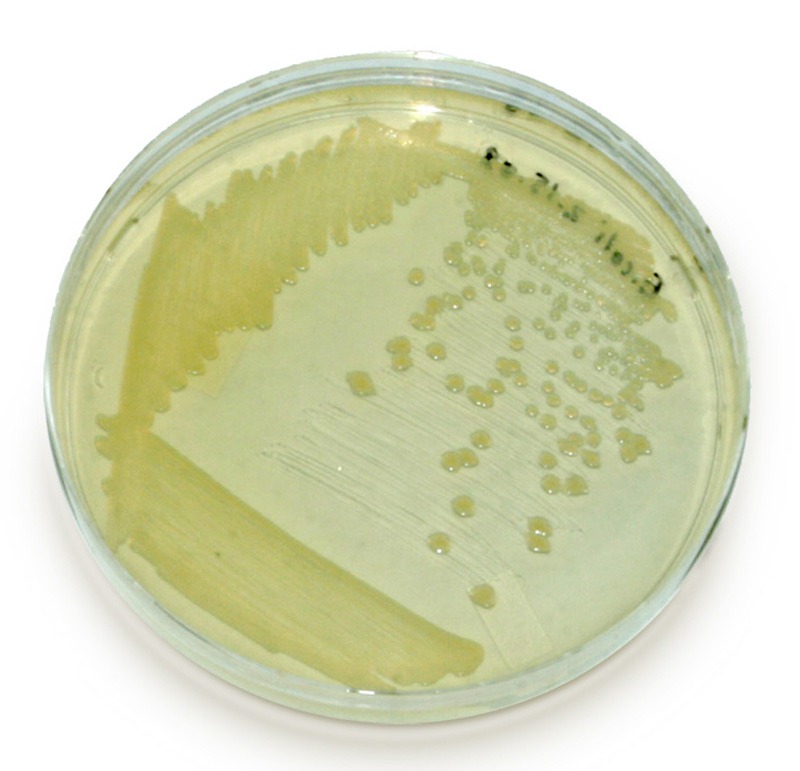
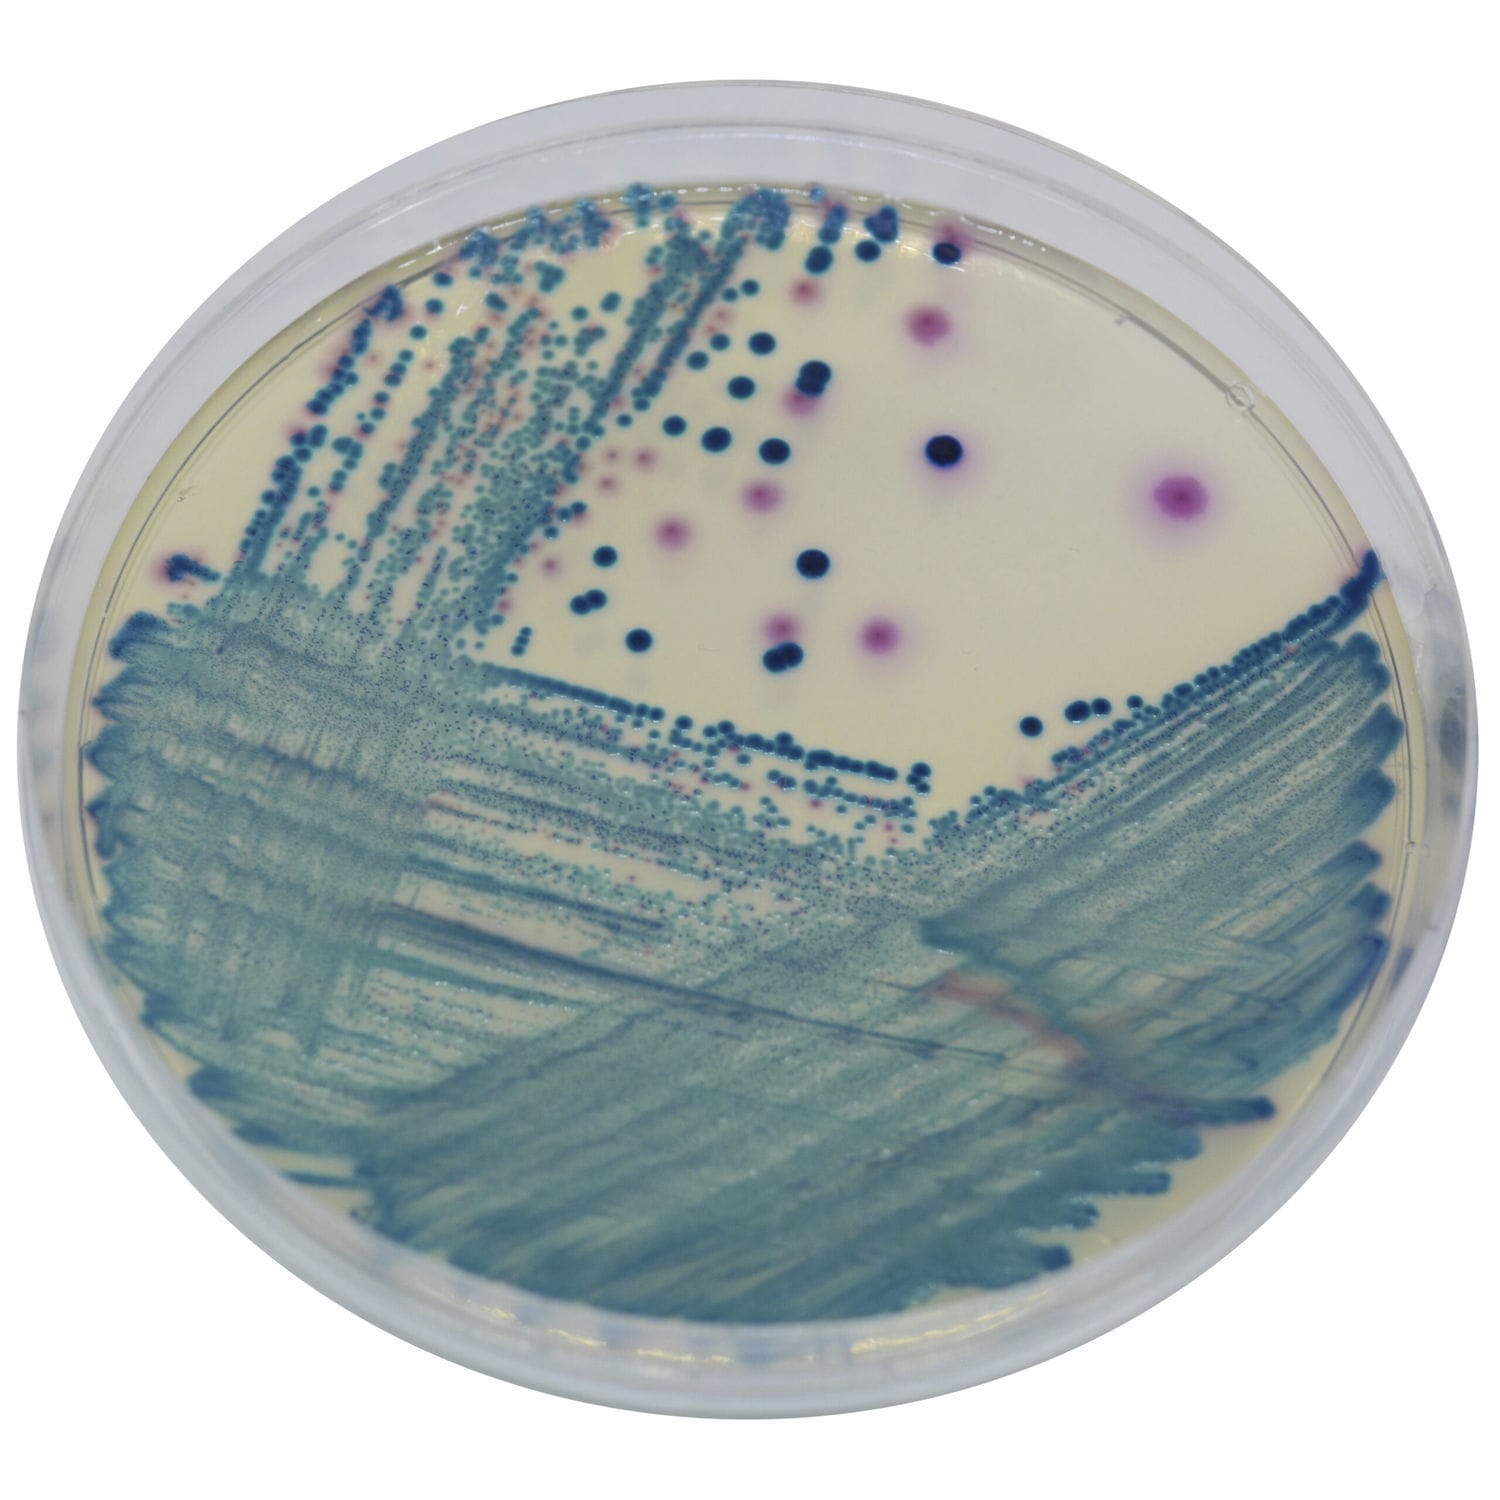

Агар кристенсена
Агар кристенсена 144 фотографий
Социальное регулирование по адресату
Методика оценки уровня общительности в ф ряховского
С ниной новые расклады сегодняшние
Поздравить римму с днем рождения
Amazfit a2026
Правила слушания и ведения беседы
Гбуз 131 филиал 4
Особенности строения и образа жизни млекопитающих таблица
Практика жилищник
Переплата по ипотеке за 30 лет